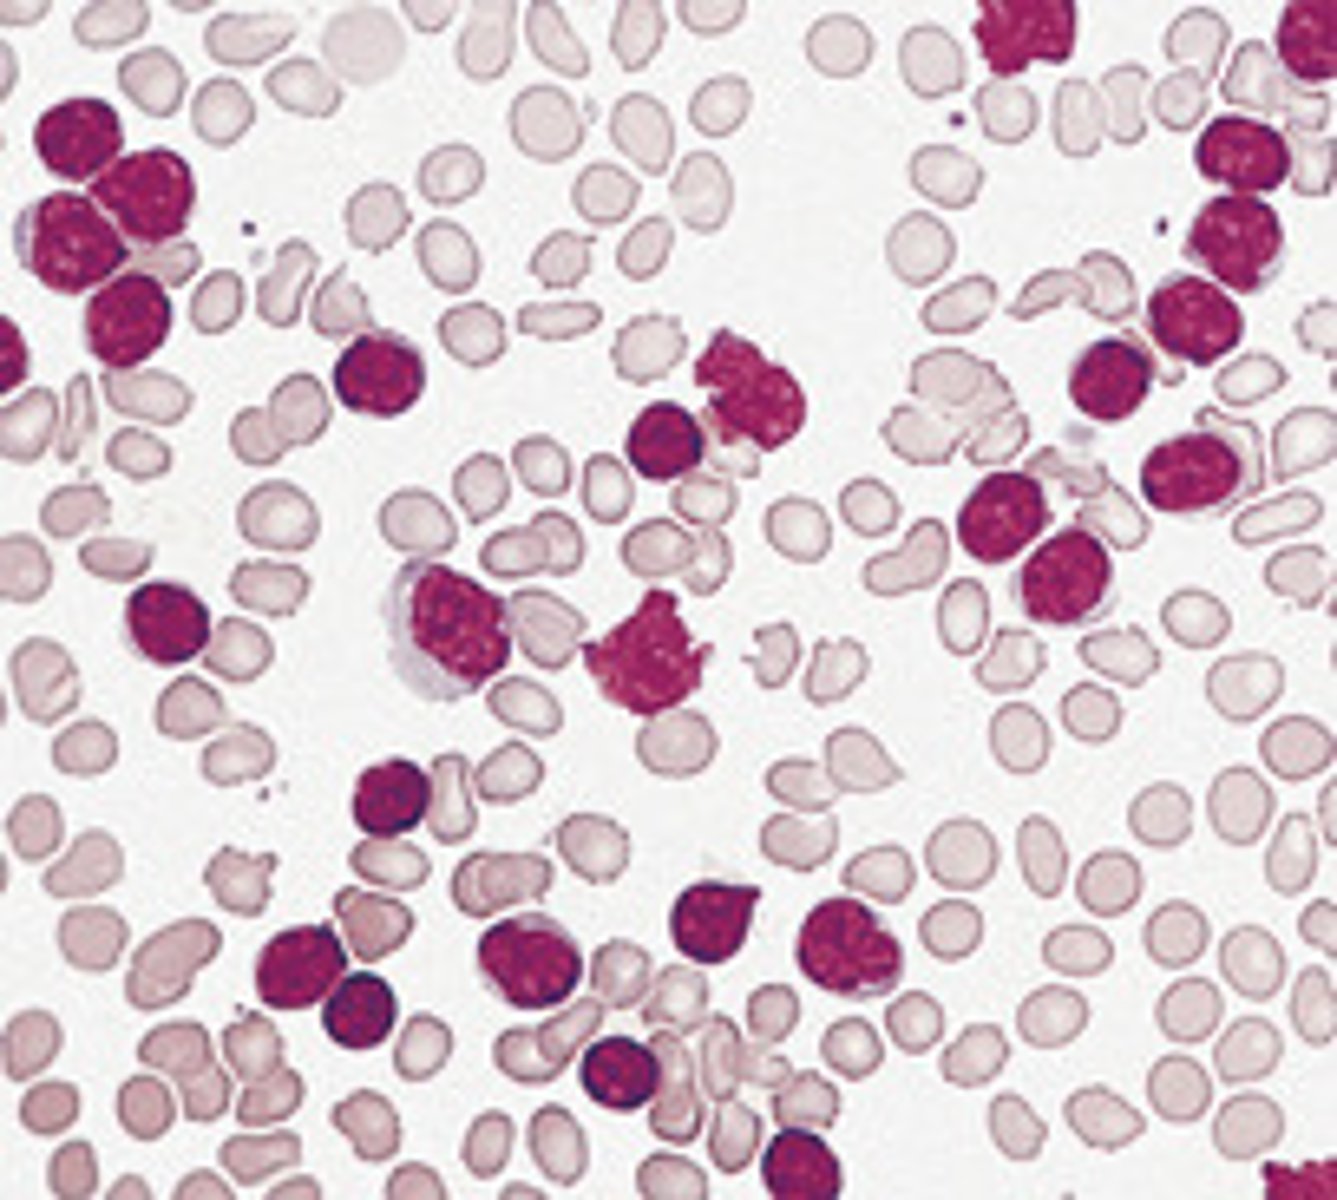
<p>antibodies</p>
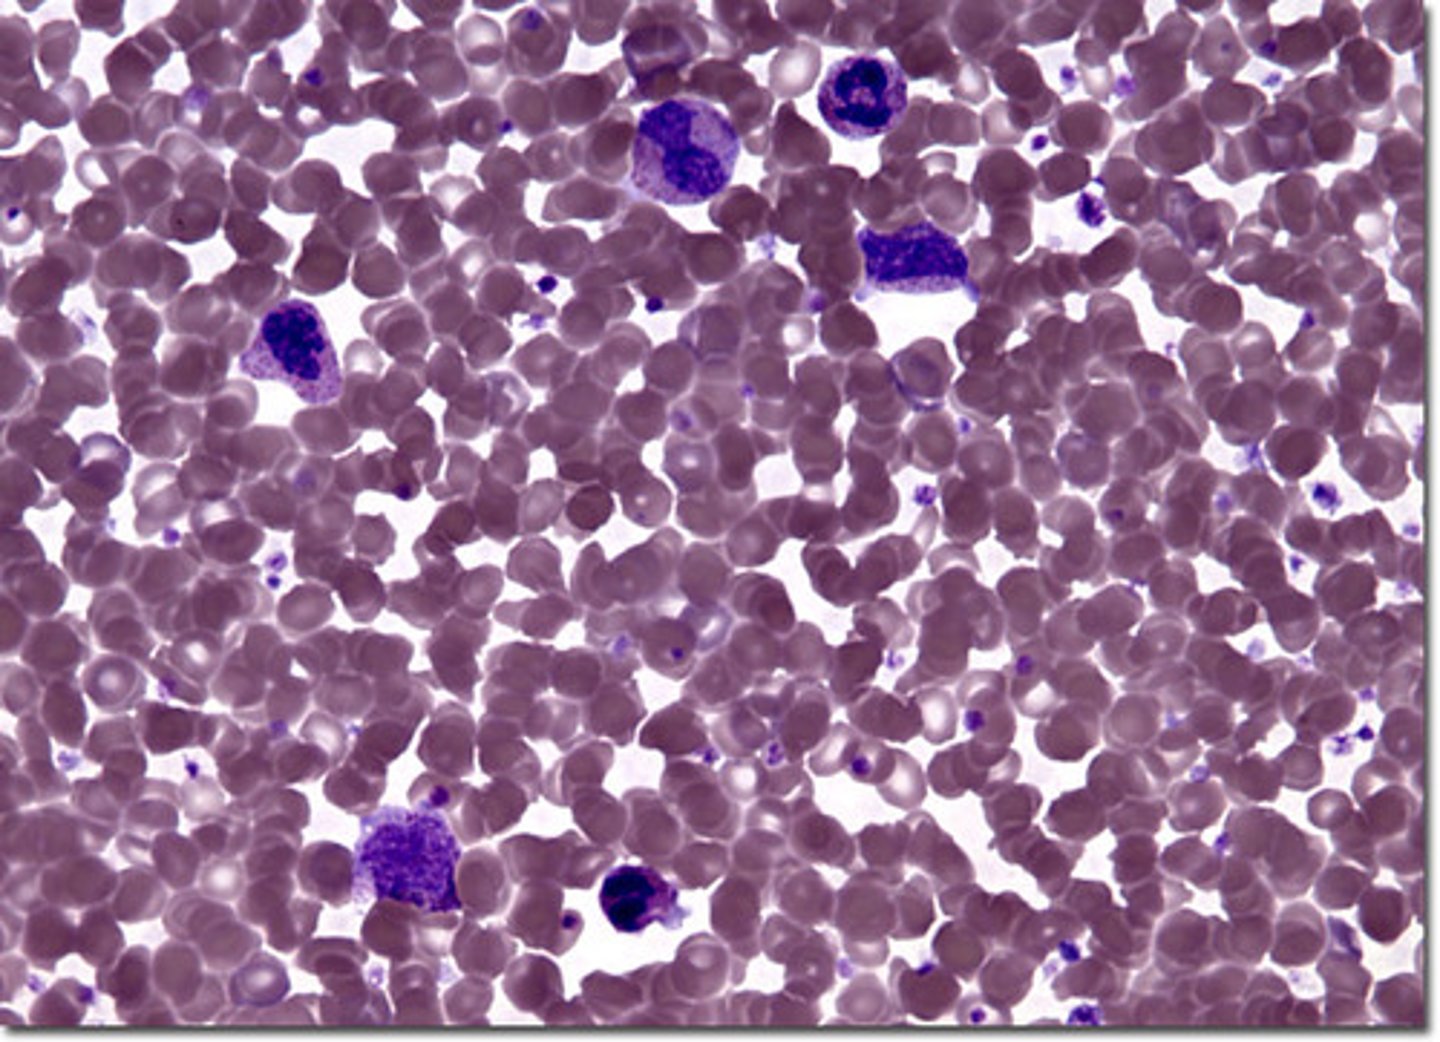
<p>A disorder characterized by an abnormal increase in the number of red blood cells in the blood</p>

1/55
Looks like no tags are added yet.
Name | Mastery | Learn | Test | Matching | Spaced | Call with Kai |
|---|
No analytics yet
Send a link to your students to track their progress
gases, nutrients, wastes
function of blood - transportation
maintains body fluid homeostasis, pH, body temp
function of blood - regulation
clotting, defensive responses
function of blood - protectio
hematocrit
percentage of blood volume occupied by red blood cells

plasma
Fluid portion of blood

plasma proteins
protein dissolved in blood plasma

7% protein, 92% water, 1% other
distribution of plasm
maintain plasma colloid osmotic pressure
function of plasma proteins
albumins
Transport fatty acids and steroids, help regulate osmotic pressure of the blood.

globulins
antibodies
fibrinogen
plasma protein that is converted to fibrin in the clotting process

albumin, globulin, fibrinogen
3 plasma proteins
most abundant, transport steroids and fatty acids, buffering, osmotic pressure
albumin
alpha and beta transport iron, lipids, fat soluble vitamins, gamma are antibodies
globulins
blood clotting
fibrinogen
serum
plasma without clotting factors

Erythrocytes
red blood cells, carry oxygen

leukocytes
white blood cells, fight infection

platelets
blood clotting

transport oxygen from lungs to body cells, co2 from body cells to lungs
erynthorcytes
neutrophils
A type of white blood cell that engulfs invading microbes and contributes to the nonspecific defenses of the body against disease.

basophils
A circulating leukocyte that produces histamine.

eosinophils
a white blood cell containing granules that are readily stained by eosin.

monocytes
An agranular leukocyte that is able to migrate into tissues and transform into a macrophage.

lymphocytes
A type of white blood cell that make antibodies to fight off infections

release chemicals, promote blood clotting, no nucleus
platelets
erynthrocytes, leukocytes, platelets
components of cellular elements
myeloid stem cell to reticulocyte, loses nucleus, forms erythrocyte
formation of RBC
myeloid stem cell to megakaryocyte to platelets
formation of platets
goes from myeoloid stem cell
formation of eosinophil, basophil, neutrophil, monocytes
lymphoid stem cell
formation of B lymphocyte, T lymphocyte, natural killer
contain hemoglobin, biconcave, strong plasma membrane
properties of RBC
reticulocytes
immature red blood cells
greater surface area to enhance diffusion, no nucleus`
what does the biconcave nature help with
glycolysis via bisphoglycerate, dpg
anaerobic metabolism of RBC
2 alpha, 2 beta each with heme group
composition of hemoglobin
Erythropoiesis
Production of red blood cells in bone marrow.

120 days
lifespan of red blood cells
hypoxia
Low oxygen saturation of the body, not enough oxygen in the blood

polycythemia
A disorder characterized by an abnormal increase in the number of red blood cells in the blood
anemia
A condition in which the blood is deficient in red blood cells, in hemoglobin, or in total volume.

hemotocrit
percentage of RBC in a volume of blood

higher than normal number of RBC, high blood viscosity, hematocrit over 55%
polycythemia
reduced capacity to deliver oxygen, fatigue, poor thriving, hematocrit less than 40%
anemia
iron deficiency anemia
anemia caused by inadequate iron intake

pernicious anemia
lack of mature erythrocytes caused by inability to absorb vitamin B12 into the bloodstream

aplastic anemia
failure of blood cell production in the bone marrow

hemolytic
destruction of red blood cells

hemorrhagic anemia
caused by blood loss

renal anemia
lack of EPO

death of rbc, globin and heme split, globin broken down into amino acids, iron removed from heme
what happens in liver, spleen, red bone marrow #1
iron attaches to transferrin, carried to red bone marrow, erythrocytes produced
what happens in liver, spleen, red bone marrow #2
non iron part of heme converted to biliverdin then to bilirubin, transported to liver by blood
what happens when iron is removed from heme,
get converted into urobilinogen in large intestine, eliminated in feces or converted into urobilin
what happens when iron is remvoed from heme #2
bilirubin
pigment released by the liver in bile

Urobilinogen
colorless compound produced in the intestine after the breakdown by bacteria of bilirubin
